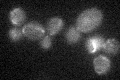
YLR067C
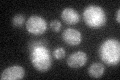
YLR067C

View description
Specific translational activator for the COX1 mRNA, also influences stability of intron-containing COX1 primary transcripts; localizes to the mitochondrial inner membrane; contains seven pentatricopeptide repeats (PPRs)
Localization:
Intensity:
Fold change:
Significance:
-
C’ GFP library in SD
mitochondria21.15 -
N' NOP1pr-GFP in SD

mitochondria29.9967 -
N' TEF2pr-mCherry in SD

punctate,mitochondria26.7571 -
N' NATIVEpr-GFP in SD

missing0 -
N' TEF2pr-VC and Cyto-VN in SD

#N/A0 -
C’ GFP library in SD+DTT
mitochondria18.520.87No -
C’ GFP library in SD+H2O2

mitochondria17.110.8Yes -
C’ GFP library in Starvation Media

mitochondria18.910.89No -
C’ GFP library on the background of Pup2-DaMP

N/A -
C’ GFP library on the background of CCT mutant

N/A0N/AYes
